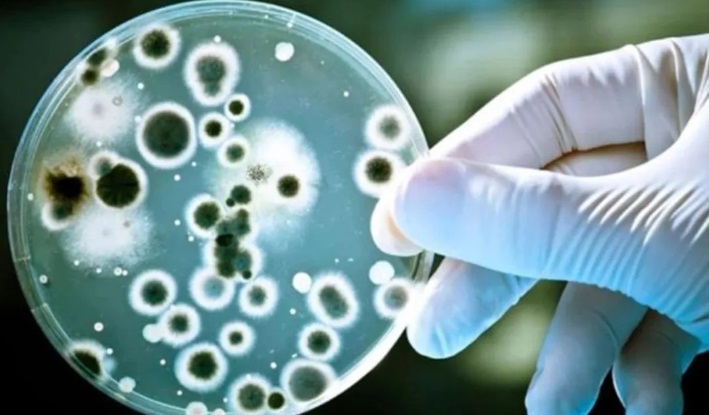

Así lo advirtió el Ministerio de Salud en un comunicado. Qué tipo de infecciones suele provocar Streptococcus Pyogenes, la bacteria responsable de la faringitis.
El Ministerio de Salud de la Nación advirtió en las últimas horas acerca de un aumento de casos por infección de una bacteria que suele causar faringitis aguda y que durante este año causó la muerte de 16 personas. Se trata de Streptococcus Pyogenes, la cual suele provocar también infecciones cutáneas como impétigo, celulitis y escarlatina.
“Durante 2023 se notificaron al Sistema Nacional de Vigilancia de la Salud (SNVS) 118 casos confirmados de infección invasiva por Streptococcus Pyogenes en todo el país, de los cuales 16 fallecieron”, señaló el comunicado de la cartera dirigida por Carla Vizzotti. La provincia de Buenos Aires, puntualizó el texto, es el distrito con mayor cantidad de casos: 35. Detrás se ubican Santa Fe, con 20; Chubut, con 10; y Tierra del Fuego con 10.
En el informe, el Ministerio de Salud detalló que se trata de una infección bacteriana que en la mayoría de los casos provoca enfermedades leves como amigdalitis, faringitis, impétigo, celulitis y escarlatina. De todos modos, alertó que en algunos casos puede derivar en cuadros agudos y severos que puede provocar condiciones potencialmente mortales, siendo responsable de más de 500.000 muertes anuales en todo el mundo.
La cartera conducida por Vizzotti señaló que desde 2018 se realiza una vigilancia específica sobre la bacteria y que en los últimos años ha habido un aumento casi exponencial de casos. ”En los años anteriores (2019-2022), el mayor número de casos se había registrado en 2022 (año cerrado) con 75 casos reportados. El número de 2023 representa un aumento del 281% respecto al mismo período de 2019″, indicó el comunicado.
El problema no se atañe solo a la Argentina, sino que fue reportado por la Organización Mundial de la Salud. “Informó que al menos cinco Estados miembros de la región europea (Francia, Irlanda, los Países Bajos, Suecia y el Reino Unido e Irlanda del Norte) habían reportado un aumento en el número de casos”, agregó el Ministerio de Salud.
La transmisión ocurre por contacto cercano con una persona infectada y puede transmitirse a través de la tos, los estornudos o el contacto con una herida.
El período de incubación para la enfermedad varía de acuerdo a la presentación clínica, entre uno a tres días. El tratamiento de las personas infectadas con antibiótico durante por lo menos 24 horas elimina por lo general su capacidad de propagación.
Cuáles son los síntomas de la faringitis
Los principales signos son dolor de garganta, fiebre, cefaleas, dolor abdominal, náuseas y vómitos, enrojecimiento de faringe y amígdalas, mal aliento y ganglios aumentados de tamaño en el cuello.
Entre las recomendaciones, se sugiere la correcta higiene de las manos para ayudar a controlar la transmisión. También, evitar la automedicación con antibióticos y realizar una consulta médica para tener diagnóstico oportuno. En el caso de recibir indicación médica de tratamiento antibiótico, es fundamental completar el esquema. Y por último, tener al día la vacunación antigripal y contra COVID-19.